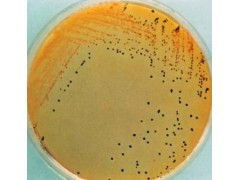

产品简介
产品名称:苯丙氨酸脱氨酶培养基产品用途及说明:用于苯丙氨酸脱氨酶试验包 装:250培养基简介:培养基的选择应根据微生物生长代
公司简介
上海仁捷生物科技有限公司 霍 手机17302193538 QQ:2450878877 座机:021-60346444
上海仁捷生物科技有限公司专业经营生产ELISA试剂盒,科研化试剂、分析试剂 ,代理许多国际先进水平的高科技产品,包括分子生物学、细胞生物学、免疫学、诊断等多个研究及应用领域。我们努力将欧美专业生产厂家的具有国际先进水平的产品推荐给各类研究人员;另一方面也非常重视自主产品研究和开发,推出了一系列具有竞争力的产品和服务。同时国家对于生物行业的发展给予了极大的重视,更多地侧重于科研的投入。
上海仁捷生物科技有限公司 霍 手机17302193538 QQ:2450878877 座机:021-60346444
上海仁捷生物科技有限公司 霍 手机17302193538 QQ:2450878877 座机:021-60346444
展开
产品说明
产品名称:
苯丙氨酸脱氨酶培养基
产品用途及说明:用于苯丙氨酸脱氨酶试验
包 装 :250
培养基简介:
培养基的选择应根据微生物生长代谢活动的需要,并有利于合成细胞物质和生物化工产品的生成。培养基中主要含有水、碳源(能源)、氮源、矿物质,有的还需要提供维生素等。在酶反应过程中,原料液中被转化的物质亦即酶的作用物,亦可称为底物。
培养基的选择一般尽可能要满足以下要求:①单位质量基质,应能产生zui大量的生物物质或生物化工产品,并且要使所产生的生物物质或生物化工产品在发酵液中的浓度zui高,产率zui高,使不需要的其他代谢产物的生成,限在zui低范围内。②培养基成本低、质量均一并随时保证提供使用。③培养基使用时,对通气、搅拌、后处理和三废治理等方面所产生的问题少。
苯丙氨酸脱氨酶培养基相关产品信息:
品红亚硫酸钠琼脂 250
Fuchsin Basic Sodium Sulfite Agar
乳糖蛋白胨培养液 250
Lactose Peptone Broth
Cary-Blair 氏运送培养基 250
Cary-Blair Transport Medium
哥伦比亚血琼脂基础 250
Columbia Blood Agar Base
亮绿乳糖培养基 250
Brilliant Green Lactose Medium
肠道菌增菌肉汤(EE肉汤) 250
Enterobacteria Enrichment Broth
TTC营养琼脂 250
TTC Nutrient Agar
LB肉汤 250
LB Broth
LB营养琼脂 250
LB Nutrient Agar
苯丙氨酸脱氨酶培养基 100
Phenylalanine Deaminase Medium
哥伦比亚MUG培养基 250
Columbia- MUG Medium
2216E琼脂 250
2216E Agar
肠球菌琼脂(胆盐-七叶苷-叠氮钠琼脂) 250
Enterococcus Agar(Bile Esculin Azide Agar)
本页产品地址:http://www.geilan.com/sell/show-2123905.html

![]()
 免责声明:以上所展示的[ 苯丙氨酸脱氨酶培养基]信息由会员[上海仁捷生物科技有限公司]自行提供,内容的真实性、准确性和合法性由发布会员负责。
免责声明:以上所展示的[ 苯丙氨酸脱氨酶培养基]信息由会员[上海仁捷生物科技有限公司]自行提供,内容的真实性、准确性和合法性由发布会员负责。